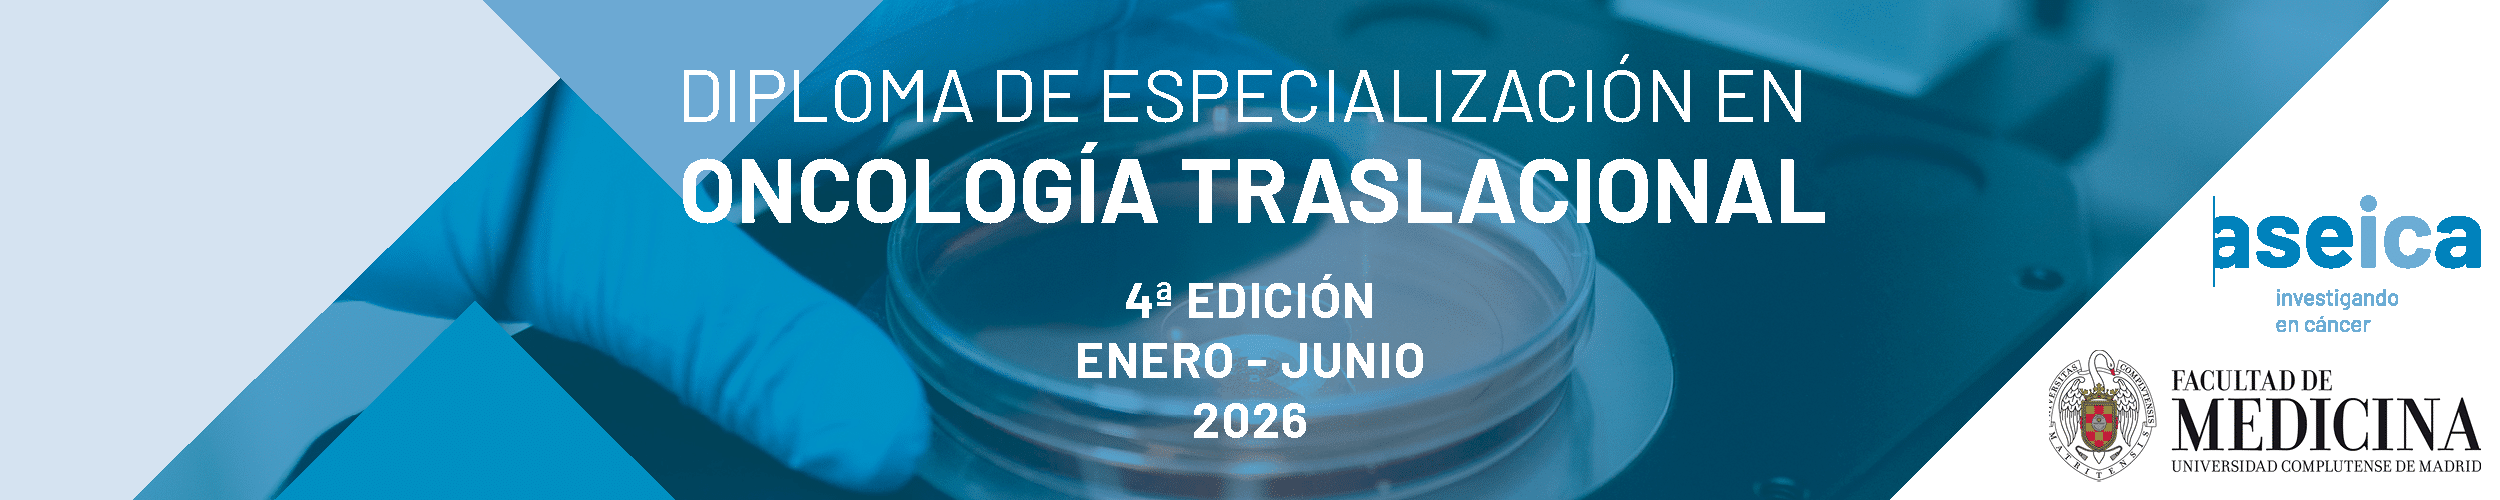
Go Norte Grupo oncológico Banner 1200

Becas GO NORTE
Convocatorias y bases de participación
Becas GO NORTE 2026
A continuación facilitamos toda la información sobre las becas de este año.
BECA GO NORTE ‘ESMO MERIT AWARD’
GO NORTE ofrece 1 beca destinada a facilitar la asistencia al congreso.
Esta beca está dirigida a residentes de 4ª y 5ª año de Oncología Médica, que hayan enviado un abstract a ESMO 2026 en el área de tumores genitourinarios, independientemente de si ha sido aceptado o no.
- El 2 de febrero se realiza la convocatoria y difusión
- El 12 de mayo 19 de mayo a las 23h finaliza el plazo de inscripción
- Durante la Reunión post congreso de la Sociedad Americana de Oncología Clínica, del 8 de junio, en formato virtual, se hará público y se entregará la Beca ESMO MERIT AWARD.
Plazo
19/05/26 (23:00h)
Número
1 beca
Dotación
Inscripción ESMO,
desplazamiento
y alojamiento*
Inscripción
Abierta
GANADORES 2026
Próximamente
BECAS GO NORTE 2026 PARA PROYECTOS DE INVESTIGACIÓN EN CÁNCER GENITOURINARIO
El programa de Becas GO NORTE, pretende estimular la investigación en la franja norte de España, con especial atención a los investigadores jóvenes o a aquellos centros que por su singularidad tienen habitualmente un más difícil acceso a programas de financiación competitiva para llevar a cabo estudios de investigación. Las Becas para Proyectos de Investigación en Cáncer Genitourinario están dirigidas a Médicos especialistas o MIR en Oncología Médica de último año.
PLAZOS DE CONVOCATORIA
- El 16 de marzo de 2026 se realiza la convocatoria y difusión.
- 14 de junio de 2026 a las 23h finaliza el plazo de presentación de proyectos.
- Durante el V GO NORTE International GU Debates se hará público el fallo y se entregarán las Becas.
GANADORES 2026
Próximamente
BOLSA DE VIAJE GO NORTE 2026 PARA ROTACIONES EXTERNAS
El objetivo de esta beca es ayudar a que residentes de 5º año y Médicos Adjuntos de Oncología Médica entre el primer y tercer año puedan realizar una estancia mínima de 2 meses en un centro hospitalario distinto del centro en el que están realizando su formación.
PLAZOS DE CONVOCATORIA
- El 2 de marzo de 2026 se realiza la convocatoria y difusión a los miembros de GO NORTE
- El 28 de junio de 2026 a las 23h finaliza el plazo de presentación de proyectos
- Durante la última semana de julio se fallará la Beca
- Durante el V GO NORTE GU Debates se hará entrega de la Bolsa de Viaje
GANADOR/A 2026
Próximamente
Diploma de Especialización en Oncología Traslacional ASEICA - UCM 2026
GO NORTE ofrece 4 becas a los socios y amigos, para cursar el Diploma de Especialización en Oncología Traslacional, organizado por ASEICA y la Universidad Complutense de Madrid (UCM) en 2026.
Para que puedas optar a las becas, necesitaremos que nos envíes la siguiente documentación:
- CVA
- Vídeo presentación (duración máxima 1 minuto): Preséntate y explícanos porqué te gustaría cursar esta formación.
- Datos personales (nombre + apellido, Institución profesional…)
- Enviar a: secretaria@gonorteoncologia.com
IMPORTANTE
- El importe de la beca no incluye los 40€ del coste de la pre-matrícula.
- La concesión de la beca está condicionada a una evaluación y a la admisión del beneficiario en el proceso de selección de la UCM.
- El beneficiario deberá ser miembro de ASEICA.
GANADORES
PROXIMAMENTE

Dra. Nuria Laínez
Miembro de la Junta Directiva de GO NORTE
Hazte socio, hazte socia
En la lucha contra los tumores genitourinarios todos y todas somos necesarios.

Dra. Nuria Lainez
Miembro de la Junta Directiva de GO NORTE